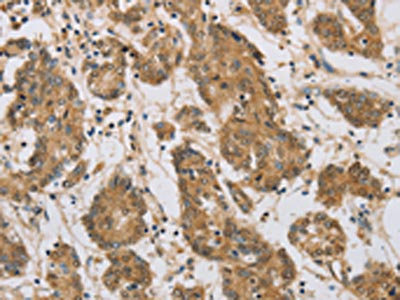

CST6 Antibody
-
中文名稱:CST6兔多克隆抗體
-
貨號:CSB-PA954269
-
規(guī)格:¥1100
-
圖片:
-
The image on the left is immunohistochemistry of paraffin-embedded Human brain tissue using CSB-PA954269(CST6 Antibody) at dilution 1/70, on the right is treated with fusion protein. (Original magnification: ×200)
-
The image on the left is immunohistochemistry of paraffin-embedded Human colon cancer tissue using CSB-PA954269(CST6 Antibody) at dilution 1/70, on the right is treated with fusion protein. (Original magnification: ×200)
-
-
其他:
產(chǎn)品詳情
-
Uniprot No.:
-
基因名:CST6
-
別名:CST 6 antibody; CST6 antibody; Cystatin 6 antibody; Cystatin E antibody; Cystatin E/M antibody; Cystatin M antibody; Cystatin M/E antibody; Cystatin-6 antibody; Cystatin-E antibody; Cystatin-M antibody; Cystatin6 antibody; CystatinE antibody; CystatinM antibody; Cysteine proteinase inhibitor antibody; CYTM_HUMAN antibody
-
宿主:Rabbit
-
反應(yīng)種屬:Human
-
免疫原:Fusion protein of Human CST6
-
免疫原種屬:Homo sapiens (Human)
-
標(biāo)記方式:Non-conjugated
-
抗體亞型:IgG
-
純化方式:Antigen affinity purification
-
濃度:It differs from different batches. Please contact us to confirm it.
-
保存緩沖液:-20°C, pH7.4 PBS, 0.05% NaN3, 40% Glycerol
-
產(chǎn)品提供形式:Liquid
-
應(yīng)用范圍:ELISA,IHC
-
推薦稀釋比:
Application Recommended Dilution ELISA 1:2000-1:10000 IHC 1:100-1:300 -
Protocols:
-
儲存條件:Upon receipt, store at -20°C or -80°C. Avoid repeated freeze.
-
貨期:Basically, we can dispatch the products out in 1-3 working days after receiving your orders. Delivery time maybe differs from different purchasing way or location, please kindly consult your local distributors for specific delivery time.
-
用途:For Research Use Only. Not for use in diagnostic or therapeutic procedures.
相關(guān)產(chǎn)品
靶點詳情
-
功能:High affinity inhibitor for cathepsin L, cathepsin L2 (cathepsin V), and legumain. Involved in the regulation of epidermal cornification, and hair follicle morphogenesis and maintenance.
-
基因功能參考文獻:
- High CST6 expression is associated with lymph-node metastasis in Triple-Negative Breast Cancer. PMID: 29530995
- Results provide evidence that cystatin E/M is a tumor suppressor gene which plays an important role in the regulation of NF-kappaB. PMID: 27090639
- Low CST6 expression is associated with breast cancer. PMID: 24742492
- Developed a Methylation-Sensitive High Resolution Melting Analysis (MS-HRMA) assay for the investigation of CST6 promoter methylation in breast cancer patients.CST6 promoter was methylated in 39/80 of FFPEs. PMID: 23088560
- The CST6 promoter is highly methylated in circulating cell-free DNA of breast cancer patients, but not in healthy individuals. PMID: 23006792
- Data show a regulatory role of cystatin E/M in controlling both intra- and extracellular legumain activity. PMID: 22902879
- The ectopic expression of CST6 in cancer cells rescued mice from overt osteolytic metastasis and deaths in the animal study, while CST6 knockdown markedly enhanced cancer cell bone metastasis and shortened animal survival. PMID: 22688893
- An association between the quantity of CST6 methylation and the expression statuses of estrogen receptor, progesterone receptor, and HER4 in tumor tissues was found PMID: 21092257
- the level of cystatin E/M regulates legumain activity and hence the invasive potential of human melanoma cells PMID: 20074384
- CST6 is not a major gene contributing to type 1 and 2 harlequin ichthyosis PMID: 12839564
- Cystatin M suppresses the malignant phenotype of MDA-MB-435S cells. PMID: 14676833
- Complete loss of expression of cystatin M was observed in two of three stage IV breast cancer patients. Immunohistochemical studies confirmed that expression of cystatin M in IDCs was partially or completely lost. PMID: 15466187
- This study thus provides the first evidence that CST6 plays a role in the modulation of genes, particularly, genes that are highly relevant to breast cancer progression. PMID: 16356477
- Identification of CTSV & CTSL as targets for cystatin M/E, their (co)-expression in the stratum granulosum of skin, and activity of CTSL toward transglutaminase 3 strongly imply an important role for them in the differentiation process of human epidermis. PMID: 16565075
- Tumors displaying CST6 gene methylation, display methylation in both ductal carcinoma in situ and invasive breast carcinoma lesions and reduced expression of cystatin M in these tumors was confirmed by immunohistochemistry PMID: 16912163
- strong link between CST6 promoter hypermethylation and loss of CST6 expression in breast cancer cell lines PMID: 17043665
- Cystatin M may encode a novel epigenetically inactivated candidate tumor suppressor gene. PMID: 17099723
- Methylation-dependent epigenetic silencing of CST6 represents an important mechanism for loss of CST6 during breast tumorigenesis and/or progression to metastasis. PMID: 17540367
- cystatin E/M is a cervical cancer suppressor gene and that the gene is inactivated by somatic mutations and promoter hypermethylation. PMID: 18506750
- results demonstrate that epigenetic silencing of CST6 is frequent in adult and pediatric brain tumors and occurs in TICs, which are thought to give rise to the tumor PMID: 18607344
- CST6, CXCL14, DHRS3, and SPP1 are regulated by BRAF signaling and may play a role in papillary thyroid carcinoma pathogenesis PMID: 18676742
- These findings imply that CST6 is likely to involve in the proliferation and survival of pancreatic cancer probably through its proteinase inhibitory activity, and it is a promising molecular target for development of new therapeutic strategies for PDAC PMID: 18754876
- The cysteine protease inhibitor cystatin M/E is a key regulator of a biochemical pathway that leads to epidermal terminal differentiation. PMID: 19005484
- Cystatin M (CST6) tumor suppressor gene is concurrently down-regulated with other loci in breast epithelial cells cocultured with cancer-associated fibroblasts. PMID: 19074894
- cystatin M/E has a role in skin barrier formation and a potential role as a tumor suppressor gene [review] PMID: 19262604
- Results suggest that the downregulation of the CST6 gene is associated with promoter histone modifications and that this association plays an important role in prostate cancer progression during the invasive and metastatic stages of the disease. PMID: 19503093
- Methylation of cystatin M promoter is associated with breast cancer. PMID: 19551853
顯示更多
收起更多
-
亞細(xì)胞定位:Secreted.
-
蛋白家族:Cystatin family
-
組織特異性:Restricted to the stratum granulosum of normal skin, the stratum granulosum/spinosum of psoriatic skin, and the secretory coils of eccrine sweat glands. Low expression levels are found in the nasal cavity.
-
數(shù)據(jù)庫鏈接:
Most popular with customers
-
-
YWHAB Recombinant Monoclonal Antibody
Applications: ELISA, WB, IHC, IF, FC
Species Reactivity: Human, Mouse, Rat
-
Phospho-YAP1 (S127) Recombinant Monoclonal Antibody
Applications: ELISA, WB, IHC
Species Reactivity: Human
-
-
-
-
-